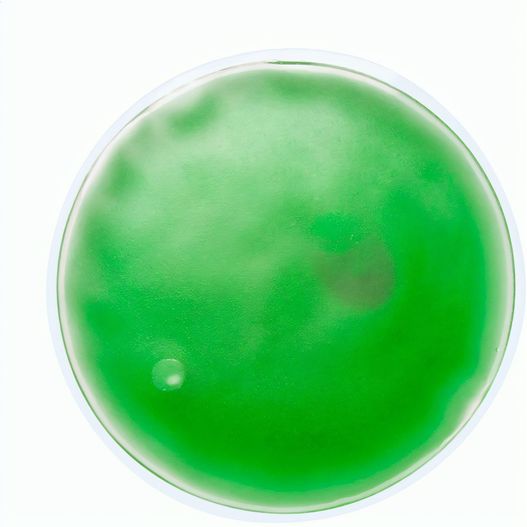
Produktabbildung Wärmekissen Relief Wärmekissen Relief (Bild 1)

Beschreibung
Das Wärmekissen Relief ist nicht nur ein stilvoller Werbeartikel, sondern bietet auch eine praktische Anwendung für jeden Tag. In der Kategorie der Wärmekissen finden Sie dieses wiederverwendbare Wärme- und Kühlkissen, das Ihnen eine angenehme Entspannung bietet. Ob zur Linderung von Verspannungen oder zur Kühlung an heißen Tagen – dieses Produkt ist ein absolutes Must-have.
Das Wärmekissen Relief ist nicht nur ein effektives Mittel zur Schmerzlinderung oder Erfrischung, sondern auch eine hervorragende Möglichkeit, Ihre Marke zu präsentieren. Durch die individuelle Bedruckung können Sie Ihre Unternehmensbotschaft gezielt an Ihre Zielgruppe kommunizieren. CRIMEX bietet Ihnen die Möglichkeit, dieses hochwertige Werbemittel als Werbelösung zu nutzen, die sowohl funktional als auch ansprechend ist. Nutzen Sie die Chance, mit einem praktischen Artikel, der im Alltag Verwendung findet, nachhaltig in Erinnerung zu bleiben.
Steigen Sie in die Welt der Werbeartikel ein und investieren Sie in das Wärmekissen Relief. Es wird nicht nur Ihren Kunden Freude bereiten, sondern auch Ihre Marke stärken!